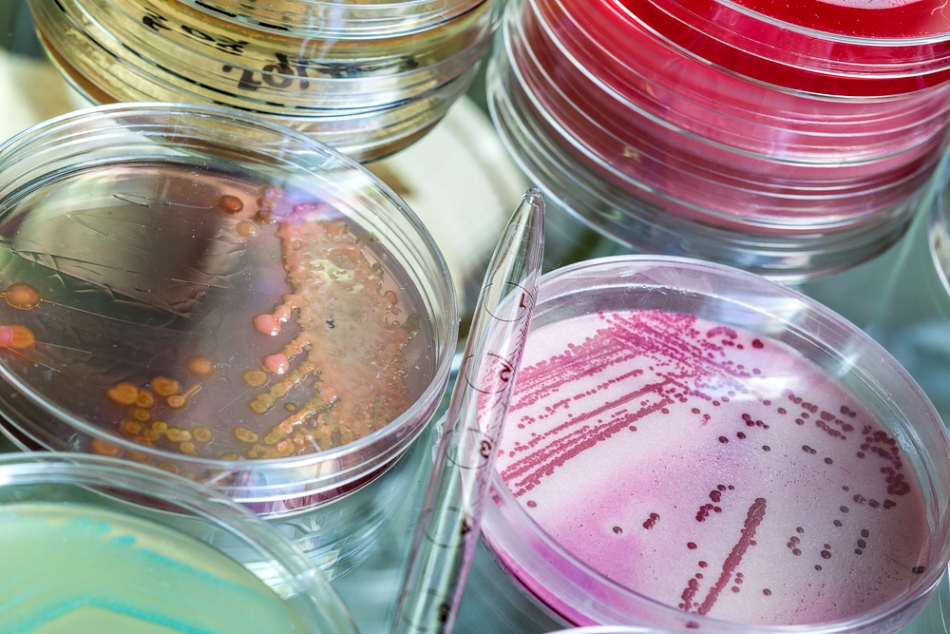
Mai puţin de 1% din totalul estimat al speciilor de microorganisme pot fi cultivate în laborator.

Ce sunt „microbii”?
Noi, cei din România, de obicei numim „microbi” microorganismele patogene care ne produc neplăceri legate de sănătate; mulţi dintre noi nu prea fac deosebire între bacterii şi virusuri (deşi din punct de vedere biologic, deosebirile dintre aceste tipuri de entităţi biologice sunt foarte mari), iar uneori, chiar şi ciuperci microscopice patogene ori vreun parazit sunt categorisite (nu de medici, desigur, ci de publicul larg de nespecialişti) drept tot un fel de „microbi”. Oricum, multă vreme criteriul de bază, pentru noi, a fost patogenitatea: microbi erau acele microorganisme care provocau boli.
În schimb, în limba engleză – în momentul de faţă limba internaţională a ştiinţei – sunt numite „microbes” o varietate largă de organisme microscopice, indiferent dacă acestea sunt sau nu patogene pentru om: bacterii, archee, fungi (ciuperci) microscopice, alge unicelulare, protozoare; câteodată sunt cuprinse în acest grup chiar şi animale microscopice. Unii cercetători includ între microbi şi virusurile, alţii însă consideră că virusurile nu sunt cu adevărat fiinţe vii, aşa că le exclud dintre „microbi”, cu toate că, tradiţional, ramura foarte complexă a ştiinţei ce studiază microorganismele – microbiologia – se ocupă şi de virusuri, în cadrul unei sub-ramuri specializate, virusologia sau virologia, cum este numită mai nou.
Cum să ne descurcăm în atâtea definiţii? Pentru scopul acestui articol, să adoptăm un punct de vedere mai restrâns, aşa cum au făcut şi cercetătorii care au reuşit, recent, să facă primii paşi în lumea necunoscută a materiei negre microbiene.
Ei s-au concentrat asupra două categorii de „microbi”: bacteriile şi archeele, pe cât de larg răspândite în biosfera terestră, pe atât de puţin cunoscute, după cum veţi vedea.
Bacteriile şi archeele, care constituie două dintre domeniile lumii vii, aşa cum este ea clasificată la ora actuală, sunt organisme microscopice unicelulare, procariote (lipsite de nucleu şi de organite celulare delimitate de membrane), cu materialul genetic organizat sub forma unui cromozom circular care pluteşte în citoplasma celulei.
Multă vreme, archeele au fost considerate tot bacterii – un subgrup aparte de bacterii, numite „arhebacterii”; în ultimele decenii, însă, cercetări mai aprofundate de microbiologie, mai ales în domeniul filogeniei moleculare (care analizează genele pentru a stabili gradul de înrudire dintre diferite specii) au arătat că archeele nu seamănă îndeajuns de mult cu bacteriile pentru a fi puse laolaltă cu acestea. Ele au, în structura şi funcţia celulei, unele caracteristici prin care se aseamănă cu bacteriile, dar şi altele prin care se deosebesc net de acestea, apropiindu-se în schimb de eucariote (organismele ale căror celule au materialul genetic conţinut în nucleu). Una peste alta, archeele formează un grup cu trăsături aparte, aşa că au fost scoase din rândul bacteriilor şi instalate într-un loc al lor: domeniul Archaea.
Prin urmare, bacteriile şi archeele sunt „microbii” noştri de azi, microorganismele despre care vom vorbi – atât cât se ştie despre ele. În ciuda multor decenii de studiu, descoperirea materiei negre microbiene a arătat că, de fapt, ştim încă foarte puţin.
O lume stăpânită de microbi
Viaţa pe Pământ, aşa cum o cunoaştem noi, n-ar fi posibilă fără microorganisme, afirmă Christian Rinke, unul dintre cercetătorii care studiază cel mai intens aceste forme de viaţă. O mare parte din oxigenul pe care îl respirăm e produs de microbi; cu ajutorul lor producem alimente precum iaurtul, brânza, berea şi vinul; în industria farmaceutică, microorganisnmele sunt utilizate drept micro-uzine, pentru a produce, de pildă, insulina necesară diabeticilor.
Trăim cu adevărat într-o lume stăpânită de aceste forme de viaţă. Noi n-am putea trăi fără ele, dar ele s-ar descurca de minune fără noi.
Microorganismele constituie aproximativ 60% din biomasa terestră şi se găsesc… dar unde nu se găsesc? Numărul microorganismelor dintr-o linguriţă plină cu pământ e mai mare decât cel al tuturor oamenilor de pe planetă. Apa oceanelor e plină de ele – de la apele călduţe din lagunele tropicale până la cele îngheţate ale Antarcticii şi cele fierbinţi din preajma izvoarelor vulcanice submarine. Trăiesc în fel de fel de medii de viaţă, pe crestele munţilor şi în nisipul deşertului, în reactoarele nucleare şi în organismul uman.
Iar din enorma varietate de microorganisme, nu cunoaştem decât o foarte mică parte.
Cauza? Microbiologii studiază, în general, aceste forme de viaţă cultivându-le în laborator, pentru a obţine un număr suficient de celule microbiene care să le permită să facă diferite teste şi să extragă din ele ADN, pentru a-l analiza.
Dar microorganismele ce pot fi cultivate pe medii artificiale, în laborator, sunt o minoritate. Se estimează că abia 1% dintre specii pot fi crescute astfel, pe medii de cultură. În rest, în noi şi în jurul nostru există o întreagă lume de forme de viaţă necunoscute, despre care ştim frustrant de puţin.
Dar, recent, noi metode de studiu în domeniul geneticii au permis cercetătorilor să arunce o privire în această lume misterioasă.
„Materia neagră” a biosferei
Un colectiv numeros de cercetători (peste 20), în frunte cu Christian Rinke, specialistul deja menţionat – colectiv care a publicat de curând un articol pe această temă în revista Nature – a aplicat o metodă numită single cell sequencing (o secvenţiere „celulă cu celulă”), care are marele avantaj de a permite secvenţierea genomului (ansamblul genelor unui organism) fără a fi necesară cultivarea acelui organism în laborator. În esenţă, metoda presupune amplificarea de un miliard de ori a ADN-ului unei singure celule microbiene (copierea lui de multe ori, pentru a obţine o cantitate suficientă de ADN, care să poată fi analizată).
Primul pas este prelevarea unei probe biologice, a unui eşantion de material din mediu, conţinând microorganisme. Apoi, celulele microbiene din eşantion sunt efectiv alese una câte una, prin intermediul unui aparat de sortare ce detectează celulele cu ajutorul unui laser şi le separă – fiecare celulă fiind inclusă într-o picătură minusculă de lichid – cu ajutorul forţei electrostatice.
Apoi, cercetătorii iau la rând fiecare celulă astfel obţinută, încercând să afle ce este, din ce grup face parte. Pentru asta, mai întâi înlătură învelişul celulei, pentru a avea acces la conţinutul ei, unde se găseşte ADN-ul. Adaugă un cocteil de substanţe ce conţine o enzimă numită phi29, care are capacitatea de a amplifica lanţuri foarte lungi de ADN – adică de a favoriza copierea lor de foarte multe ori – şi, după ce lasă enzima să-şi facă treaba timp de câteva ore, obţin miliarde de copii ale genomului microbian şi se pot apuca de secvenţierea lui, aflând astfel ce gene conţine.
Au reuşit, astfel, să descifreze secvenţa de gene a 201 specii de microorganisme noi pentru ştiinţă şi aşa de puţin similare cu cele cunoscute anterior, încât cercetătorii au fost nevoiţi să deseneze noi ramuri pe „arborele vieţii” – arborele filogenetic al vieţuitoarelor – pentru a găzdui formele de viaţă nou-descoperite. Creaturile proaspăt identificate au luat loc pe 29 de „ramuri”, dintre care unele erau abia schiţate, iar altele niciodată imaginate până atunci.
Şi acesta e abia începutul. Cunoaşterea noastră în privinţa biodiversităţii microbiene a planetei rămâne în continuare foarte lacunară. Cu alte cuvinte, arborele vieţii mai are o mulţime de ramuri necercetate.
Viaţa din adâncul planetei
Un alt pas a fost făcut anul acesta, în urmă cu doar câteva săptămâni, când, la o conferinţă ştiinţiifcă desfăşurată în California, două cercetătoare din SUA, Beth Orcutt, de la Bigelow Laboratory for Ocean Sciences din East Boothbay şi Jill Banfield de la University of California, Berkeley, au prezentat, separat, comunicări privind rezultatele studiilor lor asupra formelor de viaţă microbiene din unele habitate cu condiţii neobişnuite de viaţă. Microorganismele studiate de ele trăiesc în adâncul pământului, unele în apele freatice, altele încă mai adânc, sub scoarţa terestră.
Jill Banfield a folosit, în studiul condus de ea, o abordare „în forţă”, cum spune autoarea unui articol publicat în New Scientist asupra acestor descoperiri. Metoda ei, numită metagenomică, presupune secvenţierea „la grămadă” a genoamelor tuturor organismelor dintr-o probă de sol sau apă – un fel de „recensământ genetic”, după expresia aceleiaşi autoare. Prin intermediul acestei abordări, se obţin informaţii despre bogăţia formelor de viaţă dintr-un ecosistem şi despre modul în care acestea interacţionează unele cu altele.

Dar secvenţierea genoamelor a zeci sau sute de specii diferite dintr-o dată este foarte dificilă, aşa că Jill Banfield a trebuit să găsească o soluţie de a facilita analiza. Ea a folosit o metodă computerizată avansată, utilizând algoritmi foarte sofisticaţi pentru a reasambla digital porţiuni scurte de ADN, obţinând genoame întregi. Cu ajutorul acestei metode, ea şi colaboratorii ei au identificat microorganismele ce trăiau în apa dintr-o pânză freatică din statul Colorado. Unele dintre acestea sunt foarte rare, alcătuind mai puţin de 0,1% din vieţuitoarele ecosistemului.
Analiza a identificat unele specii cunoscute, dar şi multe complet nestudiate. Mulţi dintre aceşti microbi misterioşi au celule foarte mici, cu genoame de dimensiuni reduse, ce conţin gene necunoscute cercetătorilor. În cazul a 50% dintre genele din aceste genoame, nu se ştie ce funcţii îndeplinesc, spune cu mirare Jill Banfield. Multe dintre speciile descoperite sunt complet necunoscute, nu seamănă cu nimic din ceea ce a fost studiat până acum în culturi de laborator, dar sunt înrudite între ele, alcătuind un grup aparte – încă o ramură nouă pe arborele filogenetic al vieţuitoarelor!
Şi surprizele nu se opresc aici. Unele dintre aceste microorganisme par nu prezinte metabolism, deci nu s-ar putea hrăni singure şi ar trebui să se bazeze pe alte specii pentru a supravieţui. (Una dintre consecinţele acestui fenomen este faptul că ele nu pot creşte pe mediile de cultură folosite în mod obişnuit în laborator, ceea ce ar explica de ce au rămas până acum necunoscute.)
Beth Orcutt, pe de altă parte, s-a concentrat asupra unui alt habitat prea puţin studiat până acum în ceea ce priveşte speciile pe care le adăposteşte: cursurile de apă ascunse în adâncul pământului, sub planşeul submarin, ce curg prin fisuri ale scoarţei terestre, aflate la mare adâncime. Iar cercetările ei au arătat că acolo există o întreagă lume subpământeană, necunoscută, plină de secrete, unde forme de viaţă stranii – prin comparaţie cu cele pe care le cunoaştem deja – trăiesc în condiţii extreme, netulburate poate de sute de milioane de ani.
Pentru a ajunge la aceste creaturi, Beth Orcutt şi echipa ei au folosit puţuri săpate – cu ajutorul unor instalaţii de forare de mare adâncime – în lanţul de munţi submarini Juan de Fuca, din nord-estul Pacificului, o regiune unde se întâlnesc mai multe plăci tectonice. Cu ajutorul unui vehicul subacvatic telecomandat, cercetătorii au colectat apă din aceste puţuri, apă care, cred ei, nu provine din ocean, ci s-a infiltrat din cursurile de apă de sub fundul oceanului. Ar fi, probabil, cea mai primitivă şi neatinsă apă care poate fi obţinută din biosfera marină de mare adâncime, crede Orcutt.
Echipa ei a folosit metoda secvenţierii „celulă cu celulă” şi, ca şi Jill Banfield, a descoperit o mulţime de specii noi pentru ştiinţă, iar descoperirea lor ridică o serie de întrebări pe cât de dificile, pe atât de pasionante.
Cea dintâi întrebare ar fi: cum supravieţuiesc aceste organisme? Sau, mai exact, ce „mănâncă” ele?
Analiza genelor lor sugerează că ar consuma metan; nu e un lucru surprinzător în sine, căci în lumea bacteriilor sunt cunoscute multe specii care folosesc metanul drept sursă de energie. Ciudăţenia e alta: de unde îşi procură metanul, de vreme ce sub şirul de munţi submarini Juan de Fuca nu prea există metan, după cum au arătat studii geologice anterioare?
Cercetări viitoare vor trebui să elucideze acest mister, printre multe altele. Unul dintre cele mai incitante domenii ale microbiologiei actuale, studiul materiei negre microbiene (de altfel, prezentă şi în microbiomul uman, care e departe de a-şi fi dezvăluit secretele) va aduce, cu mare probabilitate, în anii următori, un număr considerabil de descoperiri uimitoare. Ştim încă foarte, foarte puţin despre aceste creaturi cu care împărţim Pământul şi dintre care multe trăiesc în condiţii extreme, ducând o viaţă ale cărei mecanisme scapă deocamdată înţelegerii noastre. Ceea ce ştim cu siguranţă este că există, mai peste tot în jurul nostru, o întreagă lume de fiinţe nevăzute, pe cât de mici, pe atât de însemnate în viaţa planetei şi pe care abia începem să le cunoaştem.
